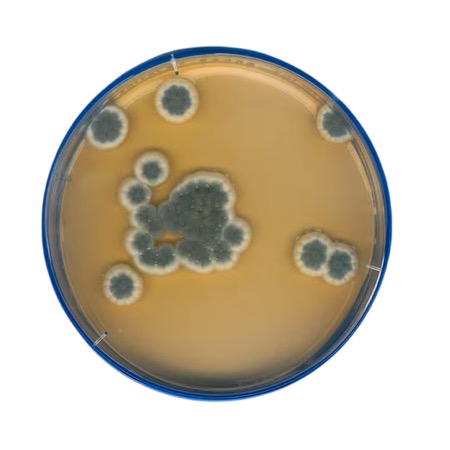
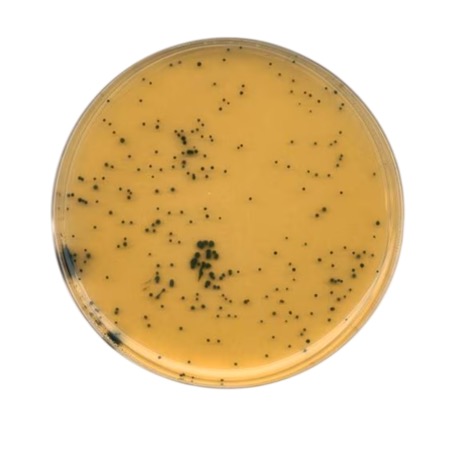
product
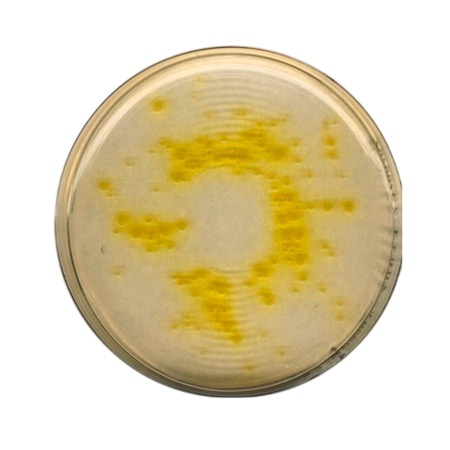
product

Granulated Sabouraud Dextrose Agar with 4 % dextrose (EP 5.6, USP 29, JP 4.05) designed for cultivation and enumeration of yeasts and molds in microbiological quality control and testing.
Sabouraud Dextrose Agar, catalogue No. 105438, is a high-quality dehydrated culture medium supplied by MilliporeSigma / Merck under the GranuCult® prime segment. It is formulated with peptones and 4 % dextrose (glucose) and is compliant with compendial requirements (EP 5.6, USP 29, JP 4.05). This medium provides an acidic environment favourable for the growth and enumeration of yeasts and molds while suppressing many bacterial contaminants. After dissolution and sterilization, the agar solidifies into a gelatinous medium suitable for routine microbiological culture of fungal flora.
Advantages
- High-quality GranuCult® prime dehydrated medium designed for fungi cultivation.
- Contains 4 % dextrose to support growth of yeasts and molds.
- Complies with pharmacopoeial standards (EP 5.6, USP 29, JP 4.05).
- Suitable for routine quality control and microbial enumeration.
- Powdered formulation allows consistent preparation of agar plates or broths.
- Reliable performance in pharmaceutical, food, beverage and environmental labs.
Technical specifications
| Product name | Sabouraud Dextrose Agar |
| Catalogue number | 105438 |
| Brand / quality | GranuCult® prime |
| Form | Dehydrated granular medium |
| Compendial compliance | EP 5.6, USP 29, JP 4.05 |
| Dextrose content | 4 % |
| Suitable for | Yeasts; molds |
| Technique | Microbiological culture |
| Typical use | Pharmaceutical, food, beverage and environmental QC |
| Prepared pH | 5.6 (65 g/L at 25 °C after autoclaving) |
| Solubility | 65 g/L in water |
| Bulk density | ~680 kg/m³ |
| Storage conditions | 15–25 °C, dry |
| Brand | Merck |
| Pack size | 500 g |